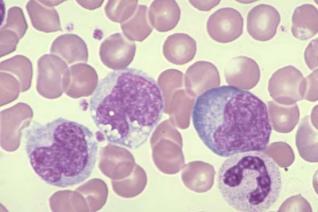
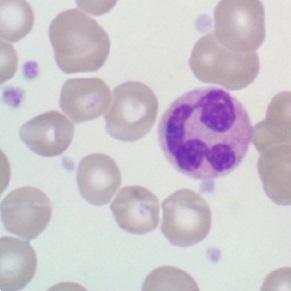

O que são os monócitos


Os monócitos são células presentes no sangue, fazendo parte do sistema imunitário do corpo humano. São um dos cinco tipos de leucócitos, ou seja, glóbulos brancos, e circulam na corrente sanguínea juntamente com hemácias (glóbulos vermelhos) e trombócitos (plaquetas), envoltos em plasma. Na imagem ao lado os monócitos são as células maiores.
Onde são produzidos
Os monócitos, sendo uma das células constituintes do sangue, são produzidas no mesmo sítio do corpo humano onde este se produz: na medula óssea. A partir daí circulam na corrente sanguínea por algumas horas até chegarem ao seu destino: os tecidos, onde desempenham sua função passando a se chamar macrófagos.
Qual a sua função
Dado que os monócitos são um tipo de glóbulo branco, sua função é proteger o organismo de invasores, ou corpos estranhos. Atuam na remoção de células mortas, de células tumorais, combatem vírus e bactérias evitando desta forma o desenvolvimento de infeções e algumas doenças, que tanto podem ser agudas, como febre, ou graves, como anemia.

Valores de referência de monócitos
Os níveis normais de monócitos presentes no sangue variam entre 0-12% ou 90-900/mm3. Quando estes valores se elevam (monócitos altos) significa que os monócitos foram produzidos em quantidade maior para controlar alguma infeção, se os níveis se apresentam mais baixos (monócitos baixos) significa que eles estão a resistir à própria infeção ou a pessoa em questão se encontra desnutrida.
Saiba mais no artigo: Quais são os valores normais de monócitos.
Este artigo é meramente informativo, no umCOMO não temos capacidade de receitar nenhum tratamento médico nem realizar nenhum tipo de diagnóstico. Convidamos você a recorrer a um médico no caso de apresentar qualquer tipo de condição ou mal-estar.
Se pretende ler mais artigos parecidos a O que são os monócitos, recomendamos que entre na nossa categoria de Doenças e Efeitos Secundários.